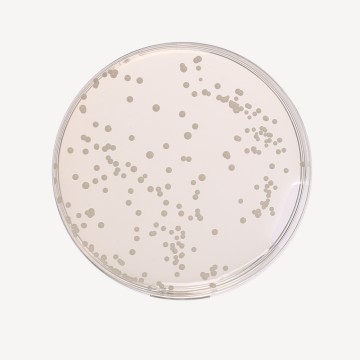
Sabouraud Dextrose Agar, Granulated

Your enquiry has been submitted
Potato Dextrose Agar, Granulated
Aspergillus#CC293D
Intended use
Recommended for the isolation and enumeration of yeasts and moulds from water, dairy and other food products and clinical samples.
Composition
| Ingredients | g/L |
|---|---|
| Potatoes, infusion from 200g | 4.000 |
| Dextrose (Glucose) | 20.000 |
| Agar | 15.000 |
| Final pH (at 25°C) | 5.6±0.2 |
Formula adjusted, standardized to suit performance parameters
Directions
Suspend 39.0 grams in 1000 ml purified/distilled water. Heat to boiling to dissolve the medium completely. Sterilize by autoclaving at 15 lbs pressure (121°C) for 15 minutes. Cool to 45-50°C. Mix well before dispensing into tubes or flasks as desired. In specific work, when pH 3.5 is required, acidify the medium with sterile 10% tartaric acid. The amount of acid required for 100 ml of sterile, cooled medium is approximately 1 ml. Do not heat the medium after addition of the acid.
Principle And Interpretation
Potato Dextrose Agar is recommended by APHA (1) and F.D.A.(2) for plate counts of yeasts and moulds in the examination of foods and dairy products (3). Potato Dextrose Agar is also used for stimulating sporulation, for maintaining stock cultures of certain dermatophytes and for differentiation of typical varieties of dermatophytes on the basis of pigment production (4). It is also recommended by USP (5), BP (6), EP (3) and JP (7) for growth of fungi. Potato infusion and dextrose promote luxuriant fungal growth. Adjusting the pH of the medium by tartaric acid to 3.5, inhibits the bacterial growth. Heating the medium after acidification should be avoided as it may hydrolyse the agar which can render the agar unable to solidify.
Type of specimen
Clinical samples- skin scrapings, nail scrapings, etc. food and dairy samples; Water samples
Specimen Collection and Handling:
For clinical samples follow appropriate techniques for handling specimens as per established guidelines (8,9).
For food and dairy samples, follow appropriate techniques for sample collection and processing as per guidelines (1,10).
For water samples, follow appropriate techniques for sample collection, processing as per guidelines and local standards (11).
After use, contaminated materials must be sterilized by autoclaving before discarding.
Warning and Precautions
In Vitro diagnostic Use. For professional use only. Read the label before opening the container. Wear protective gloves/protective clothing/eye protection/ face protection. Follow good microbiological lab practices while handling specimens and culture. Standard precautions as per established guidelines should be followed while handling clinical specimens. Safety guidelines may be referred in individual safety data sheets.
Limitations :
- Heating the medium after acidification should be avoided as it may hydrolyse the agar which can render the agar unable to solidify.
Performance and Evaluation
Performance of the medium is expected when used as per the direction on the label within the expiry period when stored at recommended temperature.
Quality Control
Appearance
Cream to yellow granulated free flowing powder
Gelling
Firm, comparable with 1.5% Agar gel
Colour and Clarity of prepared medium
Yellow coloured clear to slightly opalescent gel forms in Petri plates.
Reaction
Reaction of 3.9% w/v aqueous solution at 25°C. pH: 5.6±0.2
pH
5.40-5.80
Cultural Response
Cultural characteristics observed after an incubation at 22 - 25°C for 4 - 5 days.
| Organism | Growth | Ascospore formation |
|---|---|---|
| # Aspergillus brasiliensis ATCC 16404 (00053*) | luxuriant | Negative |
| Candida albicans ATCC 10231 (00054*) | luxuriant | Negative |
| Saccharomyces cerevisiae ATCC 9763 (00058*) | luxuriant | Positive |
Key: (#) - Formerly known as Aspergillus niger, (*) - corresponding WDCM numbers
Storage and Shelf Life
Store between 10-30°C in a tightly closed container and the prepared medium at 20-30°C. Use before expiry date on the label. On opening, product should be properly stored dry, after tightly capping the bottle inorder to prevent lump formation due to the hygroscopic nature of the product. Improper storage of the product may lead to lump formation. Store in dry ventilated area protected from extremes of temperature and sources of ignition. Seal the container tightly after use. Product performance is best if used within stated expiry period.
Disposal
User must ensure safe disposal by autoclaving and/or incineration of used or unusable preparations of this product. Follow established laboratory procedures in disposing of infectious materials and material that comes into contact with clinical sample must be decontaminated and disposed of in accordance with current laboratory techniques (8,9).
Reference
- Salfinger Y., and Tortorello M.L., 2015, Compendium of Methods for the Microbiological Examination of Foods, 5th Ed., American Public Health Association, Washington, D.C.
- FDA Bacteriological Analytical Manual, 2005, 18th Ed., AOAC, Washington, DC.
- European Pharmacopoeia, 2022, 10 th volume, European Directorate for the quality of medicines & Healthcare.
- MacFaddin J. F., 1985, Media for the Isolation-Cultivation-Identification-Maintenance of Medical Bacteria, Vol.1, Williams and Wilkins, Baltimore
- The United States Pharmacopoeia-National Formulatory (USP-NF), 2022.
- The British Pharmacopoeia, 2022, Medicines and Healthcare products Regulatory Agency.
- Japanese Pharmacopoeia, 2016.
- Isenberg, H.D. Clinical Microbiology Procedures Handbook. 2nd Edition.
- Jorgensen, J.H., Pfaller, M.A., Carroll, K.C., Funke, G., Landry, M.L., Richter, S.S and Warnock., D.W. (2015) Manual of Clinical Microbiology, 11th Edition. Vol. 1.
- Wehr H. M. and Frank J. H., 2004, Standard Methods for the Microbiological Examination of Dairy Products, 17th Ed., APHA Inc., Washington, D.C.
- Lipps WC, Braun-Howland EB, Baxter TE,eds. Standard methods for the Examination of Water and Wastewater, 24th ed. Washington DC:APHA Press; 2023.
| Product Name | Potato Dextrose Agar, Granulated |
|---|---|
| SKU | GM096 |
| Product Type | Granulated |
| Physical Form | Granular |
| Origin | Animal Free (Veg) |
| Packaging type | HDPE |
| References | 1.Downes F. P. and Ito K., (Eds.), 2001, Compendium of Methods for the Microbiological Examination of Foods, 4th Ed.,APHA, Washington, D.C. 2.FDA Bacteriological Analytical Manual, 2005, 18th Ed., AOAC, Washington, DC. 3.Wehr H. M. and Frank J. H., 2004, Standard Methods for the Microbiological Examination of Dairy Products, 17th Ed.,APHA Inc., Washington, D.C. 4.MacFaddin J. F., 1985, Media for the Isolation-Cultivation-Identification-Maintenance of Medical Bacteria, Vol.1, Williamsand Wilkins, Baltimore5.The United States Pharmacopoeia, 2016, The United States Pharmacopoeial Convention. Rockville, MD. 6.British Pharmacopoeia, 2016, The Stationery office British Pharmacopoeia7.European Pharmacopoeia, 2014, European Dept. for the quality of Medicines. 8.Japanese Pharmacopoeia, 2008. |